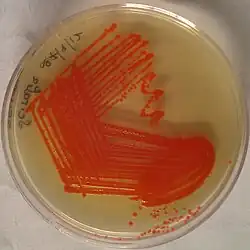

Colonial morphology

In microbiology, colonial morphology refers to the visual appearance of bacterial or fungal colonies on an agar plate. Examining colonial morphology is the first step in the identification of an unknown microbe. The systematic assessment of the colonies' appearance, focusing on aspects like size, shape, colour, opacity, and consistency, provides clues to the identity of the organism, allowing microbiologists to select appropriate tests to provide a definitive identification.
Procedure

When a specimen arrives in the microbiology laboratory, it is inoculated into an agar plate and placed in an incubator to encourage microbial growth. Because the appearance of microbial colonies changes as they grow, colonial morphology is examined at a specific time after the plate is inoculated. Usually, the plate is read at 18–24 hours post-inoculation,[1]: 163 but times may differ for slower-growing organisms like fungi.[2]: 518 The microbiologist examines the appearance of the colony, noting specific features such as size, colour, shape, consistency, and opacity.[1]: 165–8 A hand lens or magnifying glass may be used to view colonies in greater detail.[3]: 96
The opacity of a microbial colony can be described as transparent, translucent, or opaque. Staphylococci are usually opaque,[1]: 167–8 while many Streptococcus species are translucent.[4]: 188 The overall shape of the colony may be characterized as circular, irregular, or punctiform (like pinpoints). The vertical growth or elevation of the colony, another identifying characteristic, is assessed by tilting the agar plate to the side and is denoted as flat, raised, convex, pulvinate (very convex), umbilicate (having a depression in the centre) or umbonate (having a bump in the centre).[1]: 167 [5]: 19 The edge of the colony may be separately described using terms like smooth, rough, irregular and filamentous. Bacillus anthracis is notable for its filamentous appearance, which is sometimes described as resembling Medusa's head.[1]: 167
Consistency is examined by physically manipulating the colony with a sterile instrument. It is described using terms like brittle, creamy, sticky and dry. Staphylococci are considered to have a creamy consistency,[1]: 173 while some Neisseria species are sticky, and colonies of diphtheroid bacteria and beta-hemolytic streptococci are typically dry.[1]: 167–8 Bacteria that produce capsules often have a slimy (mucoid) consistency.[2]: 495
When certain microorganisms are grown on blood agar, they may digest the blood in the medium, causing visible hemolysis (destruction of red blood cells) on the agar plate. In colonial morphology, hemolysis is classified into three types: alpha-, beta-, and gamma-hemolysis. In alpha-hemolysis, the blood is partially digested, causing the area around the colony to turn green. In beta-hemolysis, the organism digests the blood completely, leaving a clear area around each colony.[1]: 165–6 Organisms that do not produce hemolysis are referred to as gamma-hemolytic.[2]: 500 Clostridium perfringens, which causes gas gangrene, is noteworthy for producing a "double zone" of both complete and incomplete hemolysis.[6]: 94
The odour of a culture is sometimes considered part of colonial morphology. While intentionally smelling microbial cultures is not advised, some organisms produce distinctive odours that can be detected during routine examination of the culture. Among these are Pseudomonas aeruginosa, which has a grape-like scent; Staphylococcus aureus, which is said to smell like old socks; and Proteus mirabilis, whose scent is alternately described as putrid[1]: 168 or like chocolate cake.[7]: 124
Other distinctive features of colonial morphology include motility and the production of pigments. Pseudomonas aeruginosa produces the pigments pyocyanin and pyoverdin, which give the colonies a greenish sheen.[1]: 473 [5]: 154 Some specimens of Serratia marcescens produce an orange-red pigment called prodigiosin.[5]: 26 [8]: 236 Organisms with swarming motility, like Proteus species, exhibit concentric waves of growth extending from the inoculation point.[1]: 423 [5]: 153
-
 Staphylococcus aureus: large opaque, round, creamy, white to yellowish colonies displaying beta-hemolysis on blood agar[1]: 167–73
Staphylococcus aureus: large opaque, round, creamy, white to yellowish colonies displaying beta-hemolysis on blood agar[1]: 167–73 -
_on_Columbia_Horse_Blood_Agar.jpg) Streptococcus pyogenes: small translucent colonies displaying beta-hemolysis on blood agar[1]: 167 [8]: 216
Streptococcus pyogenes: small translucent colonies displaying beta-hemolysis on blood agar[1]: 167 [8]: 216 -
 Streptococcus pneumoniae: small colonies with raised edges displaying alpha-hemolysis on blood agar[8]: 223
Streptococcus pneumoniae: small colonies with raised edges displaying alpha-hemolysis on blood agar[8]: 223 -

-
Serratia marcescens: red pigmentation: although considered characteristic of the species, only about 10% of specimens produce this pigment[8]: 236
Serratia marcescens: red pigmentation: although considered characteristic of the species, only about 10% of specimens produce this pigment[8]: 236 -

-

Interpretation
Colonial morphology serves as the first step in the identification of microbial species from clinical samples.[10] Based on the visual appearance of the colonies, microbiologists can narrow down the list of possible organisms, allowing them to select appropriate tests to provide a definitive diagnosis. For example, if a microbiologist observes colonies that resemble a Staphylococcus species, they may perform a catalase test to confirm that it belongs to the genus Staphylococcus, and a coagulase test to determine whether it is a coagulase-negative staphylococcus or a more pathogenic species, such as S. aureus.[3]: 101 [8]: 203
Observation of hemolysis is useful in the presumptive identification of bacteria,[1]: 165–6 especially streptococci, which are classified on the basis of their hemolytic reactions.[11]: 92 For example, Streptococcus pyogenes, which causes strep throat and scarlet fever,[12] displays beta-hemolysis, while Streptococcus pneumoniae, which can cause pneumonia and meningitis, displays alpha-hemolysis.[2]: 507 The highly pathogenic S. aureus classically displays beta-hemolysis,[5]: 26 while Staphylococcus epidermidis, part of the normal skin flora and an occasional opportunistic pathogen, does so weakly or not at all.[1]: 309–14
Although automated techniques like MALDI-TOF are increasingly used to identify microorganisms in clinical laboratories, colonial morphology remains useful to distinguish potential pathogens, which must be identified, from normal flora, for which definitive identification is unnecessary,[1]: 163 and to confirm identification when automated techniques give inconclusive results.[3]: 103–4
References
- ^ a b c d e f g h i j k l m n o p q Connie R. Mahon; Donald C. Lehman; George Manuselis (18 January 2018). Textbook of Diagnostic Microbiology. Elsevier Health Sciences. ISBN 978-0-323-48212-7.
- ^ a b c d Mary Louise Turgeon (2016). Linné & Ringsrud's Clinical Laboratory Science: Concepts, Procedures, and Clinical Applications. Elsevier Mosby. ISBN 978-0-323-22545-8.
- ^ a b c Gary W. Procop; Elmer W. Koneman (2017). Koneman's Color Atlas and Textbook of Diagnostic Microbiology. Wolters Kluwer Health. ISBN 978-1-4511-1659-5.
- ^ P. J. Quinn; B. K. Markey; F. C. Leonard; P. Hartigan; S. Fanning; E. S. Fitzpatrick (7 October 2011). Veterinary Microbiology and Microbial Disease. John Wiley & Sons. ISBN 978-1-118-25116-4.
- ^ a b c d e f Michael J. Leboffe; Burton E. Pierce (1 January 2012). A Photographic Atlas for the Microbiology Laboratory. Morton Publishing Company. ISBN 978-1-61731-007-2.
- ^ Apurba Sankar Sastry; Bhat Sandhya K (20 August 2017). Essentials of Practical Microbiology. JP Medical Ltd. ISBN 978-93-5270-185-8.
- ^ Luis M. de la Maza; Marie T. Pezzlo; Cassiana E. Bittencourt; Ellena M. Peterson (16 June 2020). Color Atlas of Medical Bacteriology. John Wiley & Sons. ISBN 978-1-68367-035-3.
- ^ a b c d e Karen C. Carroll; Janet S. Butel; Stephen A. Morse (12 August 2015). Jawetz Melnick & Adelbergs Medical Microbiology 27 E. McGraw-Hill Education. ISBN 978-0-07-182503-0.
- ^ M. R. Adams; M. O. Moss (2008). Food Microbiology. Royal Society of Chemistry. ISBN 978-0-85404-284-5.
- ^ Bae, Euiwon; Kim, Huisung; Rajwa, Bartek; Thomas, John G.; Robinson, J. Paul (2015). "Current status and future prospects of using advanced computer-based methods to study bacterial colonial morphology". Expert Review of Anti-infective Therapy. 14 (2): 207–218. doi:10.1586/14787210.2016.1122524. ISSN 1478-7210. PMID 26582139. S2CID 38205341.
- ^ Karin C. VanMeter; Robert J. Hubert; William G. VanMeter (7 August 2013). Microbiology for the Healthcare Professional. Elsevier Health Sciences. ISBN 978-0-323-27702-0.
- ^ Androulla, Efstratiou; Theresa, Lamagni (10 February 2016). "Epidemiology of Streptococcus pyogenes". Streptococcus pyogenes : Basic Biology to Clinical Manifestations. Oklahoma City, United States: University of Oklahoma Health Sciences Center. Retrieved 6 March 2020.
See also
- Bacterial cellular morphologies—the microscopic appearance of bacterial cells